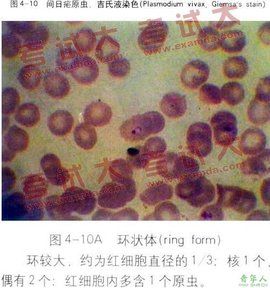
間日瘧 間日瘧

疾病簡介
瘧疾
間日瘧瘧疾(malaria)是因瘧原蟲寄生人體組織而引起的寄生原蟲病。臨床上以間歇性發冷、發熱、肝脾腫大為主要特徵。主要包括間日瘧、惡性瘧、三日瘧和卵形瘧。
間日瘧
拼音:jiànrìnüè
英文名:tertian malaria;[vivax malaria;]
中華按蚊由;平原地區間日瘧傳播的主要媒介是中華按蚊。
病原學
間日虐原蟲各時期圖間日瘧的病原體是間日瘧原蟲。瘧原蟲的生活史比較複雜,它需要兩個宿主,即終宿主雌性按蚊和中間宿主人。當感染有瘧原蟲的按蚊叮咬人時,將瘧原蟲的子孢子帶入人體血液,子孢子隨即侵入肝細胞,發育為裂殖體,成熟後肝細胞破裂,而釋放出大量裂殖子,侵入血液循環中的紅細胞,進入紅細胞內發育和繁殖。
目前認為間日瘧原蟲的子孢子有速髮型和遲髮型兩種,前者在侵入肝細胞後如上所述迅速發育為裂殖體釋放入血液,侵入紅細胞進行發育。後者進入肝細胞後可先不發育,稱為休眠子,經不同的靜止期後,被啟動而進行裂體增殖,產生許多裂殖子,然後侵入血液循環中的紅細胞進行發育。這是間日瘧的潛伏期有長短之分和復發的原因。
流行病學
傳染源
間日瘧的傳染源為間日瘧患者及攜帶間日瘧原蟲者。
傳播途徑
主要由按蚊傳播。也有血液傳播和母嬰傳播,但發生率低。
易感人群
人群對瘧疾有普遍的易感性,在瘧疾流行區的人群可因隱性感染而具有一定的免疫力。
瘧疾脾腫大病人及間日瘧原蟲生活史發病機制
間日瘧間日瘧原蟲在紅細胞內進行增殖時,當裂殖體成熟後,受感染的紅細胞破裂,釋放出大量裂殖子,同時也釋放大量蟲體的代謝產物及紅細胞碎片,這些物質進入血液後,刺激單核-巨噬細胞產生細胞因子,後者又刺激體溫調節中樞,引起發冷、發熱等臨床症狀。瘧原蟲侵入人體後,刺激單核—巨噬細胞的增生,以致患者的肝臟和脾臟腫大及骨髓增生。由於大量紅細胞被破壞,以致貧血日漸嚴重。
臨床表現
間日瘧的發作分三個階段。每隔一日發作一次。
1.發冷期:先感覺發冷,隨之全身肌肉抖索,稱為寒戰,皮膚蒼白並起雞皮疙瘩,此期歷時約15~60分鐘.。隨後進入發熱期。
2.發熱期:全身發熱不適,顏麵皮膚潮紅,體溫上升至40℃或以上。並伴有頭痛、全身酸痛、噁心等症狀,此期約出現2~6個小時。
3.出汗期:大汗淋漓,體溫迅速下降,甚至降正常水平以下。患者長感全身乏力、昏昏欲睡,此期歷時2~4小時。
全部間日瘧發作過程歷時約6~10小時,兩次發作間的期間,患者並無任何不適,體溫也正常。
實驗室檢查
1.厚或薄血塗片後,進行吉姆薩染色,直接鏡檢間日瘧原蟲。
2.骨髓塗片:陽性率明顯高於直接鏡檢。
3.DNA探針雜交法
診斷
1.來自間日瘧流行區或曾在流行區居住過;
2.具有典型的間日瘧發作症狀及體徵;
3.末梢血液塗厚片找到間日瘧原蟲。
鑑別診斷
應與以下疾病相鑑別。
1.上呼吸道感染:無寒戰現象。
2.傷寒:傷寒中毒症狀明顯,呈無欲狀,有相對緩脈,少數有玫瑰疹,白細胞明顯減少,血清肥達氏反應陽性,血培養可培養出傷寒桿菌。
3.敗血症:中毒症狀明顯,常有皮膚破損,白細胞明顯增多,中性粒細胞增加。
治療
病原治療
1.首選氯喹,第一天服2次,每次0.3g,第2、3天各服0.45g,總劑量為1.5g;同時服伯氨喹,每日1次,每次15mg,連服14天,也可每天服22.5mg,連服8天。
2.青蒿素及衍生物:
⑴雙氫青蒿素,每日1次,每次80mg,首劑加倍,連服7天為1療程。
⑵青蒿琥酯:每日2次,每次50mg,首日劑量加倍,連服7天為1療程。
⑶蒿甲醚:,每日1次,每次100mg,首劑加倍,連用7天為1療程。
3.奎寧:口服,每日3次,成人每次0.6g,兒童每次10mg/kg,共3~7日
。
對症治療
對瘧疾的對症治療也非常重要。
1.高熱的處理:以物理降溫為主,必要時服用醋氯芬片(15mg/kg);
2.保持水電解質平衡;
3.糾正酸中毒;
4.輸血:重度貧血時應輸新鮮血液,是紅細胞比容保持20%以上。
預防
1.控制傳染源:治療患者及帶蟲者;
2.滅蚊、防蚊;
3.預防性服藥:可服用乙胺嘧啶等。
症狀
間日瘧原蟲經按蚊傳播而引起的寄生蟲病。瘧原蟲經血液侵入肝細胞和紅細胞內寄生繁殖,使紅細胞成批破裂而發病。潛伏期短者13~15日,長者在6個月以上。部分病人可有乏力、頭痛、食慾減退等前驅症狀。典型者常呈間日定時的寒熱發作,突起畏寒,劇烈寒戰,面色蒼白,唇指發紺,繼之即出現高熱、可伴頭痛及全身酸痛,高熱後繼以大汗而...由一種瘧疾寄生蟲(間日瘧原蟲 Plasmodium vivax)引起的瘧疾,特點為每隔48小時反覆發作 平原地區間日瘧傳播的主要媒介是中華按蚊。